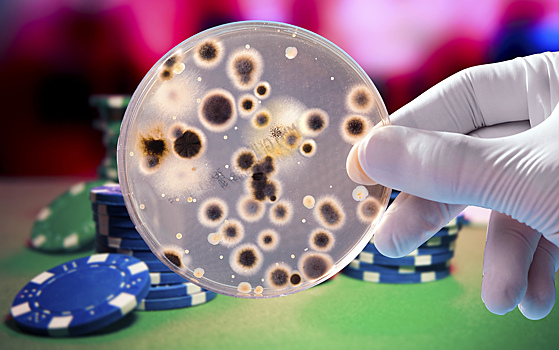
Лекторий МГУ им. М.В. Ломоносова: играют ли микробы в рулетку?

Лекторий МГУ им. М.В. Ломоносова: играют ли микробы в рулетку?
Даже точные копии организмов, выращенные в одинаковых условиях, могут в некоторых случаях проявлять разные свойства. Приносит ли это пользу или вред микробным сообществам? Чем отличается дифференцировка от разделения рисков? Что это — продуманная стратегия или неизбежные ошибки в сложных системах? На эти вопросы на примере микроорганизмов — бактерий и одноклеточных грибов — попробует ответить кандидат биологических наук, старший научный сотрудник НИИ физико-химической биологии имени А.Н. Белозерского МГУ им. М.В. Ломоносова, создатель настольной игры «Эволюция» Дмитрий Кнорре. Подписывайтесь на Indicator.Ru в соцсетях: Facebook, ВКонтакте, Twitter, Telegram, Одноклассники.